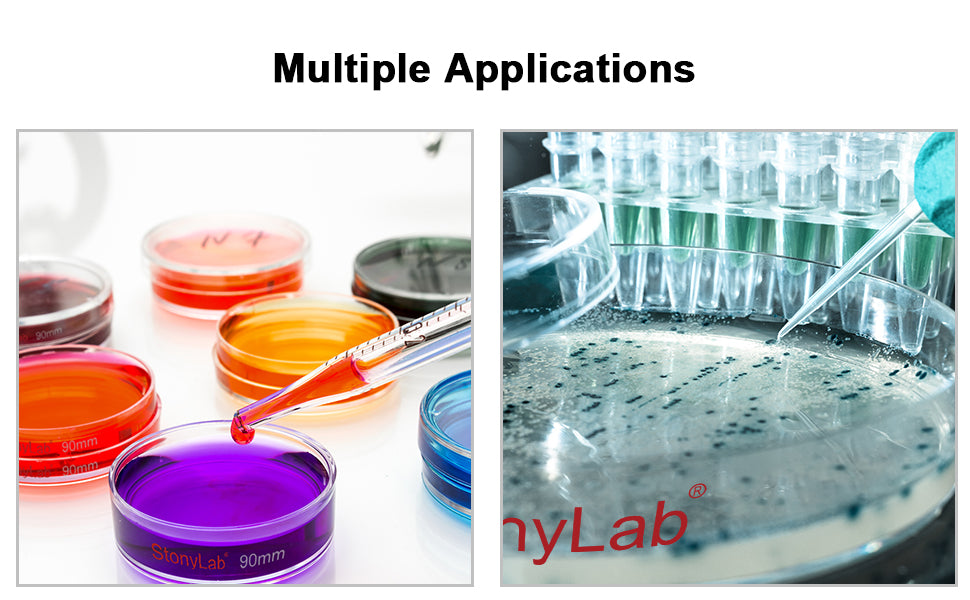

stonylab
Glass Petri Dish with Clear Lid, 1 Pack
Glass Petri Dish with Clear Lid, 1 Pack
SKU:
Couldn't load pickup availability
Processing: 1-3 business days. Shipping: 3-7 business days.
- 1 pack; 60 mm diameter and 15 mm height; 75 mm diameter and 15 mm height; 90 mm diameter and 20 mm height; 100 mm diameter and 20 mm height
- Ideal for manufacturing industry and general laboratory use like cultivation of microorganism, plant germination, cell culture, precipitate drying, and more
- Made of Borosilicate glass
- Warranty: StonyLab 1-year limited warranty; if received damaged, please contact us immediately; we will solve it until satisfied
Glass Petri Dish with lid, optically clear for easy viewing
Contact Us
Contact Us
100% Satisfaction! Please feel free to contact us anytime. All your questions will be answered within timely manner.
Shipping Worldwide
Shipping Worldwide
Yes, StonyLab offers delivery service to customers worldwide! Free standard shipping on labware orders in the US.
2-Year Warranty
2-Year Warranty
Rest easy knowing that all web registered members receive a 1-Year Comprehensive Warranty and an additional 1-Year Limited Warranty on their purchases.
Price Adjustment
Price Adjustment
Buy with confidence! Our 10-day Price Adjustment policy ensures you get the best deal.
Share

These hold up to heat shock very well. These are much better quality than I anticipated. I bought a couple crystalization dishes from QWORK and one broke when I touched it. These are thick and solid and make nice mini crystalization dishes for significantly less money.
I thought I was getting a 5 pack of these petri dishes for $10 but I guess that's my fault. I looked over my orders description again once I received the petri dish and I read the description again and to my surprise only saw that my order included 1 petri dish which really bums me out because I could have ordered 10 of these exact same petri dishes from the same company for only $25. I can't exactly blame the company for that, I guess I must hand seen an order of these petri dishes that came in a 5 pack and thought I ordered those. I was looking at several different petri dishes from several companies and I must have ordered just the 1 instead of the 5 pack I saw somewhere. The thing in most upset about is the fact that for $10 I received only 1 petri dish and the bottom dish of the petri dish had a good size crack in the lip of the dish. Not only the, the crack clearly goes completely through the glass as you can see in my pictures I've posted. Everyone knows that one a crack starts in a piece of glass it doesn't take much for that crack to grow much bigger with just a little pressure so now I'm worried about actually using the petri dish and placing the top piece on the bottom cracked piece because I'm worried that by doing so I could easily make the crack much bigger or even have a piece break off from the bottom dish. How can I receive a refund or get a replacement for this petri dish. I've never had to worry about something like this with an order before. I'm really hoping the company that supplied this petri dish will do the right thing and either refund my cost or replace my order without any hassle. I just received the package today and I opened it right away and noticed the crack instantly. It was packaged pretty well too so I'm not sure how this happened but I do know that this crack wasn't caused by me.
Best Seller
-
Lab Continuous Radiation Microwave Chemical Reactor, Rotating Turntable/Magnetic Stirring
Regular price From $1,480.00 USDRegular priceUnit price / per -
Lifting Rotary Single or Dual Jacketed Glass Reactor Systems, 20L
Regular price $9,150.00 USDRegular priceUnit price / per -
Separatory Funnel with 24/29 Joint, PTFE Stopcock, 60-2000 ml
Regular price From $22.99 USDRegular priceUnit price / per -
Digital Magnetic Stirring Heating Mantle with Temperature Probe, 250-1000 ml, RT-300°C, 20-1200 RPM
Regular price From $146.99 USDRegular priceUnit price / per -
Low Temperature Cooling Circulator Pump, 3-9L, -40-100°C, 12-28L/min Circulation Flow Rate
Regular price From $1,899.00 USDRegular priceUnit price / per
- Choosing a selection results in a full page refresh.
- Opens in a new window.
















